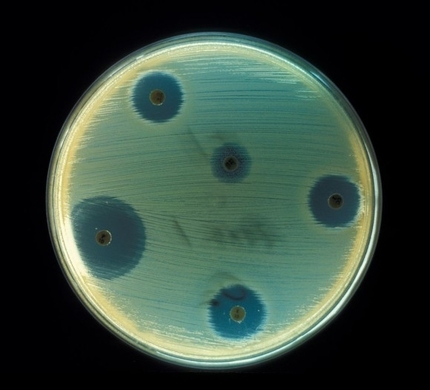

Dec 17, 19 · 第三の目が開眼すると何ができるのか? では、『第三の目』を開眼させることでどんなことができるようになるのでしょうか。 直感力 第一に、直観力が冴えます。 脳の松果体の部位に位置しているため、体の成長やホルモンに影響を及ぼします。Feb 19, · 霊感やスピリチュアルの話でよく聞く「 第三の目 」。 開眼させることで、『今まで視えなかったものが視えるようになる』と言います。 第三の目って本当にあるの? 自分の第三の目って開いてるのかな? 第三の目を覚醒させたい! といった、 スピリチュアルな能力 に憧れている方は、「第三の目」について一度は考えたことがあるのではないでしょうかApr 13, 21 · 第三の目が開眼すると見えないものが見えてくる 第三の目が開くと、下記の3つの効果が表れます。 直感力や霊感が上がる;

6vkhc6hmuyawwm
第三の目 開眼 ニキ
第三の目 開眼 ニキ-詳細 第三の目を開眼して見えたもの。 エレキバン方式は脳に悪影響がある可能性があります。 絶対に真似をしないでください。 秋美 さんのボード「 身体 」で、他にもたくさんのピンを見つけましょう。 保存元: youtubecom 驚愕第三の目と松果体について。 わずか8歳の天才黒人少年が明かした松果体の重要性とは?Jan 31, 21 · 真の開眼をした第三の目の力 = 万物の声を聞く力 = 古代文字を読み解く力 三つ目族に「古代文字を読み解く力」があるとすれば、世界政府がその存在を無視するはずがありません。 三つ目族が希少である理由 もそこにあるのかもしれません。 ロジャーの「万物の声を聞く力」については、レイリーが「なぜロジャーが古代文字を操れたのか」というロビンの



第三の目を開く方法 サードアイの場所と開眼や覚醒について ひなっち Pスタイル ひなたひでとし Note
Nov 16, 17 · いわゆる"第3の目"と呼ばれ、眉間にある6番目のチャクラがサードアイだ。 ヨガや瞑想などによってサードアイを"開眼"できるといわれてMar 24, 19 · ピップエレキバンでチャクラが開眼? ! テーマ: ブログ 眉間に位置するチャクラが 第三の目 と呼ばれています。 第6番目のチャクラとしてサードアイとも呼ばれています。 サードアイが覚醒するとどういう事があるのか?Apr 07, 21 · 皆さんは「第三の目」を知っていますか? はたまた開眼していますか?? 目が3つあるの?胡散臭い?•••などと色々と想像してしまうと思います。今回は自分自身経験を含めた『第三の目』開眼についてお話をしていきたい思います。 中々スピリチュアルでありながらも現実味のある内
Dec 11, · にゃんこ大戦争における、ネコフラワーの評価と使い道を掲載しています。ネコフラワーのステータスや特性、解放条件や進化前・進化後のキャラ、にゃんコンボなど、あらゆる情報を掲載しています。ぜひご覧ください。Oct 01, 15 · 1万年前から"秘密裏"で伝わる「開眼修行」へ潜入 第三の目。別名「サードアイ」。眉間に眠るもう一つの「目」を開眼できる修行があるという。この目を開眼すると「世界を見通すことができる」らしい。 「先住民マオリ」たちが多く住むニュージーランド北島で"指圧マッサージ"を受黒ひげ海賊団メンバーが黒ひげにつく真の理由は第三の目one piece考察 ワンピース 動画ワンピース黒ひげの正体は真の開眼済みの三つ目族!?
第三の目の開眼のmixiコミュニティ。中村天音の究極な開運方法です。 治らない病気にも効果があるかも知れません。 退化してしまった「偉大な力」 太古の昔、私たち人類の祖先の額には「第三の目」が開いていたというのです。 その目Dec 11, · にゃんこ大戦争における、竜宮獣ガメレオンの評価と使い道を掲載しています。竜宮獣ガメレオンのステータスや特性、解放条件や進化前・進化後のキャラ、にゃんコンボなど、あらゆる情報を掲載しています。ぜひご覧ください。Jul , 17 · 第三の目開眼 ビッグマムは三つ目族の第三の目を開眼させた力でラフテルに行こうとしています。 具体的に第三の目がどのような力なのかはまだわかりませんが、なんとなく、ビッグマムのところでは開眼しない気がしています。



衝撃 第三の目の 開眼方法 に世界が震えた Youtube



サードアイ覚醒 サードアイが確実に開くスピリチュアル覚醒技術 第三の目開眼 21年5月29日 21年12月26日 東京or大阪 サードアイ覚醒セッション 東京都 こくちーずプロ
Aug 11, 17 · たった3日で「第3の目」を覚醒させる法! 脳の中でパチパチ音が聞こえたら「超能力」ゲットの合図! 海外ニュースサイト「Conscious Life News」が、第6のチャクラ「アージュニャー・チャクラ」として知られる「第3の目」を覚醒させる超お手軽メソッドを紹介している。Jan 12, 21 · 召喚技『第三の目、開眼』で味方全体に付与される強化で、味方全体の攻撃力が 別枠100% 強化され 通常攻撃のダメージ上限が116万付近、奥義のダメージ上限が50万増加する。Dr啓子の 松果体(第三の目)を活性化する ヴォイスヒーリング CD 松果体はおでこの真ん中、脳の真ん中にあり、自分と宇宙をつなぐ大切な内分泌腺です。


ミラクルニキ 景梓2 3 一目惚れ 攻略コーデ 万里の刀 ミラクルニキ ニキ 攻略wiki 神ゲー攻略



人間は誰もが脳内に第三の目を持っている カラパイア
Apr 30, 19 · 第三の目は、肉体でいうと、脳の松果体という部位に対応しています。 そして、この松果体は、体の成長や代謝などのホルモンに影響を及ぼします。 また、松果体は、直感と知恵に由来する場所でもあり、第三の目が開眼すると ・「ふっと、思いついた」セルフコントロールが身に付く まず、第三の目が開眼すると、 直感力 や 霊感 が上がります。Feb 16, 15 · この「トリローチャナ」は「三眼を持つ者」を意味し、実際にシヴァ神には常に第三の目が描かれます。 この第三の目にもさまざまな深い意味が伝えられていますが、その中にある愛神カーマデーヴァとの神話を通じ、霊性を育む術を教えられたことがあり


さくらいはじめブログ Pop Art Soul



第三の目 サードアイ で見えるものは 開眼させる方法と覚醒の前兆について解説
Jan 16, · 第三の目が赤くなったのは予兆だったのだろうか? しかし、赤くなって数秒で地震が来たので、予知として逃げ出すのには使えないだろう。 瞑想4回目 /1/14朝 寝る前と、起きた時、両方で瞑想すると、とにかく意識が深くなっていく。Jan 13, 17 · 第三の目とかサードアイとか開くには 厳しい修行とかして すごい時間かかるんじゃ・・と 思うかもしれません。 しかし、その先入観がすでに 開眼するうえでの障害になっています。 とりあえず、その先入観を捨てて 「私は第三の目を開く。 限界なんてApr 18, 21 · 第三の目開眼★★★自分の人生のテーマご存知ですか⁇ 占いヒーリングエステサロン 新型コロナウイルスに関する情報について ホーム ピグ アメブロ



徹底解説 サードアイ 第6チャクラ 開眼で起こる5つの変化とは 松果体活性 高次の存在 にアクセス 人間関係に悪影響も 17年11月16日 エキサイトニュース



廃墟のtwitterイラスト検索結果
May 13, 21 · 第三の目、開眼;Aug 03, · "第三の目を開く方法" についてのお話になります。 眉間にある目、チャクラ、開眼、覚醒・・・。 色んなキーワードに関連して出てくる、 第三の目ですが。 そもそも第三の目(サードアイ)とは 何でしょうか? その場所はどこにあるのでしょうか?



Qoqrl5bt2mgm


ミラクルニキ プリンセス級3 3 首相の秘書 攻略コーデ ミラクルニキ ニキ 攻略wiki 神ゲー攻略



6vkhc6hmuyawwm



第三の目開眼 超能力を手にいれる方法をガチで試してみたら Youtube



ミラクルニキ 第3章の判定とs評価コーデまとめ Gamerch



脇差極登場 ニキ推し本丸脇差和睦会議 とあるふたつの本丸の日常記録



夫婦の在り方 吹き出物に詰まっているもの きママなあさこ


人気の 糸目 動画 31本 ニコニコ動画



人間は誰もが脳内に第三の目を持っている カラパイア



Twitterで人気のイラストランキング Buhitter 全体 08 17 09 00



嘘を見抜ける サードアイとは 驚くべき意味や5つの開眼方法 7つのチャクラ ネットr


ワンピース考察 予想特集 プリンの第三の目が真の開眼をすると起こるのは



サードアイ覚醒 サードアイが確実に開くスピリチュアル覚醒技術 第三の目開眼 21年5月29日 21年12月26日 東京or大阪 サードアイ覚醒セッション 東京都 こくちーずプロ



サードアイ覚醒 サードアイが確実に開くスピリチュアル覚醒技術 第三の目開眼 21年5月29日 21年12月26日 東京or大阪 サードアイ覚醒セッション 東京都 こくちーずプロ


イベント 空の境 心の海 攻略まとめ ミラクルニキ ニキ 攻略wiki 神ゲー攻略



第三の目 サードアイ で見えるものは 開眼させる方法と覚醒の前兆について解説



週末に観たい ネットフリックスの推し番組15連発



サードアイ覚醒 サードアイが確実に開くスピリチュアル覚醒技術 第三の目開眼 21年5月29日 21年12月26日 東京or大阪 サードアイ覚醒セッション 東京都 こくちーずプロ



狼ゲーム にハマリました ミネトのブログ



第三の目は誰でも開眼できるが 絶対にやめておいた方がいい やりたい人は自己責任でお願いします Youtube 目 サブリミナル 覚醒



ミラクルニキ 第3章の判定とs評価コーデまとめ Gamerch



特命調査 天保江戸 続 七世の書付け とあるふたつの本丸の日常記録


暗越奈良街道 坂道散歩



第三の目 サードアイ で見えるものは 開眼させる方法と覚醒の前兆について解説



Twitterで人気のイラストランキング Buhitter 全体 08 17 09 00



嘘を見抜ける サードアイとは 驚くべき意味や5つの開眼方法 7つのチャクラ ネットr



パワプロアプリ 開眼春市50なんて数えるほどしか現存してないやろなぁ 矢部速報 スマホアプリ版パワプロ攻略まとめブログ



第三の目 サードアイ が開眼すると何ができるの そして その方法とは セレンディピティ



第三の目の開眼には前兆がある 第三の目が開いている人の能力と開き方 Pouchs ポーチス



わたしの 第三の目 は覚醒してる 簡単にできる開眼方法とは 占い師と弟



脇差極登場 ニキ推し本丸脇差和睦会議 とあるふたつの本丸の日常記録



刀剣乱舞6 4 池田屋一階 攻略編成パーティ ドロップ 回想 固定ルート情報など 非公式 刀剣乱舞攻略速報



夫婦の在り方 吹き出物に詰まっているもの きママなあさこ



第三の眼 松果体を鍛えてみる 6 チャクラ



逮捕された自称芸能プロデューサーさん むせび泣く 二の三サイト



嘘を見抜ける サードアイとは 驚くべき意味や5つの開眼方法 7つのチャクラ ネットr



ミラクルニキ イベント 空の境 心の海 のコーデと絆の星の集め方 Gamerch


人気の 全員参戦 動画 123本 2 ニコニコ動画



徹底解説 サードアイ 第6チャクラ 開眼で起こる5つの変化とは 松果体活性 高次の存在 にアクセス 人間関係に悪影響も 17年11月16日 エキサイトニュース



ミラクルニキ イベント 空の境 心の海 のコーデと絆の星の集め方 Gamerch



パワプロアプリ すまん確率詳しいニキに聞きたいんやけど 金チケでは体感ほとんど30パー引いて解放の時は引けないの説明出来る 矢部速報 スマホアプリ版パワプロ攻略まとめブログ



陰陽師 百目鬼 どうめき の評価と御魂 パーティ編成



松果体に働きかけ第三の目を開眼させるための動画 直観力がアップし成功を掴む きのhealing Youtube



モバマス そろそろクラリスさん開眼させてもいいのにな 本田未央ちゃん応援まとめ速報



第三の目を開く方法 サードアイの場所と開眼や覚醒について ひなっち Pスタイル ひなたひでとし Note


ミラクルニキ ジェーン3 5 母親の情報 攻略コーデ 時の魔法 ミラクルニキ ニキ 攻略wiki 神ゲー攻略


ゾロの技まとめ集ワノ国でも目が開眼されるのか かっちゃんの人気ゲーム速報



第三の目 サードアイ で見えるものは 開眼させる方法と覚醒の前兆について解説


タガタメ 誰ガ為のアルケミスト 初心者 質問スレ Part 43 画像 36枚



刀剣乱舞 特命調査 天保江戸 てんぽうえど 攻略速報 マップ レベル 回想 編成 非公式 刀剣乱舞攻略速報



全切開 二重切開ってかなり濃いよな もう整形感バリバリだよ ミニウサギはじめました ウサギとラットの飼育 ポケモンgo情報



夫婦の在り方 吹き出物に詰まっているもの きママなあさこ



第三の目 サードアイ で見えるものは 開眼させる方法と覚醒の前兆について解説



サードアイ覚醒 サードアイが確実に開くスピリチュアル覚醒技術 第三の目開眼 21年5月29日 21年12月26日 東京or大阪 サードアイ覚醒セッション 東京都 こくちーずプロ

徹底解説 サードアイ 第6チャクラ 開眼で起こる5つの変化とは 松果体活性 高次の存在 にアクセス 人間関係に悪影響も 17年11月16日 エキサイトニュース



第三の目を開く方法 サードアイの場所と開眼や覚醒について ひなっち Pスタイル ひなたひでとし Note



徹底解説 サードアイ 第6チャクラ 開眼で起こる5つの変化とは 松果体活性 高次の存在 にアクセス 人間関係に悪影響も 17年11月16日 エキサイトニュース



Twoucan マルホ の注目ツイート イラスト マンガ



パワプロアプリ 花丸モブにキャッチャー でも花丸投手育成の問題は捕手じゃなくてバックだと思うんですけど 矢部速報 スマホアプリ版パワプロ攻略まとめブログ



スパ エ メール ファンゴ シーバムクリア パック プレディアの効果に関する口コミ 人が良いと言ったものにすぐに飛びつくクソミ By 中河 乾燥肌 代後半 Lips



嘘を見抜ける サードアイとは 驚くべき意味や5つの開眼方法 7つのチャクラ ネットr


ミラクルニキ イベント 漆黒辺境 黎明前線 攻略まとめ ミラクルニキ ニキ 攻略wiki 神ゲー攻略



さらのtwitterイラスト検索結果


ミラクルニキ 第2巻 ガール級 3 7 影の城 攻略コーデ ミラクルニキ ニキ 攻略wiki 神ゲー攻略



糸目のtwitterイラスト検索結果 古い順


ワンピース考察 予想特集 プリンの第三の目が真の開眼をすると起こるのは



特命調査 天保江戸 四周目報告と七世の書付け とあるふたつの本丸の日常記録



サードアイ 第三の目 開眼のお客様が多数 アーユルヴェーダ癒しの異空間 大阪 エターナルフォーチュン 運命美容の世界 シシィのこだわりサロン



W85ewvv555qm



第三の目 サードアイ で見えるものは 開眼させる方法と覚醒の前兆について解説



刀剣乱舞 特命調査 天保江戸 てんぽうえど 攻略速報 マップ レベル 回想 編成 非公式 刀剣乱舞攻略速報



新型コロナ 変異株 n501y 都内新規感染者の6割に 二の三サイト



夫婦の在り方 吹き出物に詰まっているもの きママなあさこ



年3月版 刀剣乱舞 大阪城 地下に眠る千両箱 攻略速報 99f周回編成案 刀剣破壊あり 第19回 非公式 刀剣乱舞攻略速報



仕事 ひろし先生の教室



楽天ドラ2高田を開眼させた ダルビッシュや千賀も認める お股ニキ 理論 フルカウント 真っすぐの軌道から小さく曲げる意識でカ dメニューニュース Nttドコモ



Avflqomgptbcrm



衝撃 第三の目の 開眼方法 に世界が震えた Youtube


さくらいはじめブログ Pop Art Soul



嘘を見抜ける サードアイとは 驚くべき意味や5つの開眼方法 7つのチャクラ ネットr



人間は誰もが脳内に第三の目を持っている カラパイア



第三の目 サードアイ で見えるものは 開眼させる方法と覚醒の前兆について解説



ヒプノシスマイク D R B Bad Ass Temple ヒプノシスマイク D R B 麻天狼 ヒプノシスマイク D R B Bad Ass Temple ヒプノシスマイク D R B 麻天狼 ヒプノシスマイク Division Rap Battle 2nd D R B Bad Ass Temple Vs 麻天狼 Ototoy



Moment 36ページ目



衝撃 第三の目の 開眼方法 に世界が震えた Youtube



Pdf Effect Of Individualized Vestibular Rehabilitation Program For Patients With Refractory Dizziness 2nd Report Characteristics Of Dysfunction In Adls Analyzed By Dhi



人間は誰もが脳内に第三の目を持っている カラパイア


人気の 糸目 動画 31本 ニコニコ動画



さく ぱんつ Auf Twitter 3 支配人と再会 使用スキル 視線無効 スマイル シンプル エレガントタグ中心です 怪盗コーデが安定かな モモのコメント ひでぇ ミラクルニキ 道化師とダイヤの仮面 ミラクルニキ攻略



徹底解説 サードアイ 第6チャクラ 開眼で起こる5つの変化とは 松果体活性 高次の存在 にアクセス 人間関係に悪影響も 17年11月16日 エキサイトニュース



第三の目を開く方法 サードアイの場所と開眼や覚醒について ひなっち Pスタイル ひなたひでとし Note
0 件のコメント:
コメントを投稿